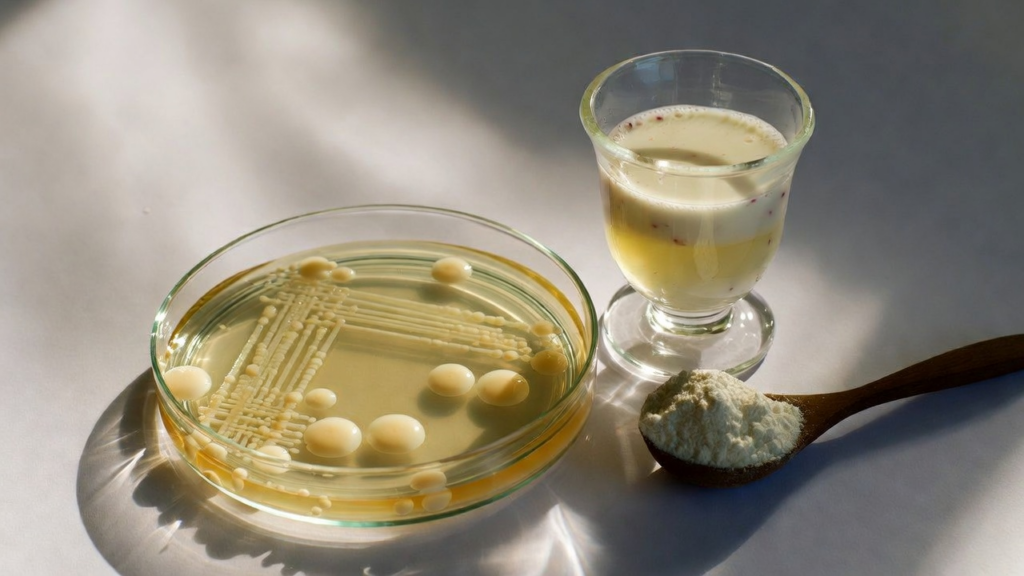
Senior pet supplements 2026: vet-approved options helping senior dogs and cats stay active and healthy with best supplements for senior dogs and supplements for senior cats

One day your dog stops racing you up the stairs or your cat hesitates before jumping onto the couch. The grey hairs are cute; the stiffness, confusion, or tummy troubles are less so. Senior pets are living longer than ever, and that means more age-related issues—but also more ways to help with senior pet supplements 2026.

Surveys from the American Pet Products Association (APPA) show that around 66–70% of U.S. households own a pet, and most owners consider those pets true family members.(petfoodprocessing.net petfoodprocessing.net) Among adults aged 50–80, 55% live with at least one pet, and over 60% say pets help them cope with physical and emotional symptoms.(ihpi.umich.edu)
At the same time, the pet dietary supplements market is exploding. Mordor Intelligence estimates it will reach USD 5.11 billion in 2026 and grow to USD 7.31 billion by 2031 at a 7.42% CAGR, driven largely by “pet humanization” and owners seeking preventive, wellness‑focused care.(mordorintelligence.com)
With shelves full of senior dog and cat supplements—many with bold promises—it’s hard to know what’s truly helpful, what’s harmless but expensive, and what might actually be risky. This 2026 guide walks you through vet-aligned, evidence-informed options for senior pet supplements 2026 so you and your veterinarian can build a smart supplement plan for your aging companion.
Before You Start: A Quick Safety Note
Always talk to your veterinarian before adding supplements.
Many supplements are safe when used correctly—but they can:
- Interact with prescription drugs (e.g., NSAIDs, anticoagulants, antiseizure meds).(dvm360.com)
- Worsen some conditions (e.g., high‑dose fish oil in pets with clotting disorders, certain herbs in liver or kidney disease).(caninearthritis.org)
- Duplicate nutrients already present in therapeutic diets, leading to excess.(todaysveterinarypractice.com)
For senior pets, a baseline exam and lab work (blood, urine ± blood pressure) before starting supplements is ideal.
Understanding Senior Pet Health Needs
There’s no single age where a pet becomes “senior,” but many vets consider:
- Dogs: roughly 7+ years (earlier for giant breeds).(mordorintelligence.com)
- Cats: often 10+ years as truly geriatric, though joint and kidney changes start earlier.(todaysveterinarypractice.com)
As pets age, certain problems become very common.
Common Health Challenges in Senior Pets
| Health Challenge | How Common? (Approximate) | Key Drivers |
|---|---|---|
| Arthritis / Joint Pain | ~20% of adult dogs overall and up to 80% of senior dogs.(frontiersin.org greyb.com) | Cartilage wear, old injuries, obesity |
| Cognitive Dysfunction | 28% of dogs 11–12 and 68% of dogs 15–16 show signs; cats also affected.(theveterinarynurse.com todaysveterinarypractice.com) | Oxidative stress, beta‑amyloid deposition |
| Digestive Issues | Chronic or recurrent diarrhea/constipation is common in older pets, especially with other disease.(mdpi.com pubmed.ncbi.nlm.nih.gov) | Microbiome shifts, reduced motility, disease |
| Weakened Immunity | Aging immune systems respond less robustly; chronic inflammation is more frequent.(mdpi.com) | Immunosenescence, oxidative damage |
| Overall Inflammation | Chronic “smoldering” inflammation underlies many senior diseases, from arthritis to cognition.(mdpi.com) | Free radicals, excess weight, joint disease |
Why Early Intervention Matters
By the time a dog is clearly lame or a cat stops jumping, joint damage is usually well established. Studies suggest osteoarthritis often begins years before diagnosis, and many affected dogs are under‑treated.(nature.com pmc.ncbi.nlm.nih.gov)
Similarly, cognitive dysfunction and subtle GI signs often get dismissed as “just old age” until they’re advanced.(todaysveterinarypractice.com)
Supplements work best when they’re part of an early, multimodal plan that also includes:
- Weight management and appropriate exercise.(caninearthritis.org)
- Pain control when needed.(dvm360.com)
- Environmental modifications (ramps, non‑slip rugs, litter box access).(greymuzzle.org)
Breed and species matter too: large‑breed dogs often need aggressive joint and weight support, while cats more often need help with kidney, joint, and digestive health.(nature.com todaysveterinarypractice.com)
For more on diet-related heart risks, check our guide on Grain Free Dog Food May Be Hurting Your Dog’s Heart.
Omega‑3s: The Anti‑Inflammatory Powerhouse

What they are: Long‑chain omega‑3 fatty acids—especially EPA and DHA—from marine sources like fish oil or green‑lipped mussel (GLM).
Why they matter for seniors:
- Joint health: Multiple randomized trials show fish‑oil diets improve mobility, weight‑bearing, and owner‑assessed comfort in dogs with osteoarthritis, sometimes allowing lower NSAID doses.(pubmed.ncbi.nlm.nih.gov pubmed.ncbi.nlm.nih.gov pubmed.ncbi.nlm.nih.gov)
- Heart and kidney support: Omega‑3s are routinely used in canine and feline heart and kidney diets to help modulate inflammation and lipids.(pubmed.ncbi.nlm.nih.gov caninearthritis.org)
- Cognitive protection: DHA and EPA, plus improved cerebral energy metabolism, are part of many senior “brain diets” for dogs and cats.(mdpi.com pubmed.ncbi.nlm.nih.gov)
Evidence Snapshot
- In one 6‑month randomized trial, dogs with osteoarthritis fed a high‑omega‑3 diet had significantly better ability to rise, walk, and play compared with controls.(pubmed.ncbi.nlm.nih.gov)
- Another study found 82% of dogs on a fish‑oil–supplemented diet improved weight‑bearing vs. 38% of controls.(pubmed.ncbi.nlm.nih.gov)
- A 2024 trial using ~70 mg/kg/day EPA+DHA for 16 weeks improved pain scores and increased the “Omega‑3 Index” in pet dogs.(pubmed.ncbi.nlm.nih.gov)
Practical Dosing (for dogs)
Reviews of canine omega‑3 trials suggest osteoarthritis benefits at roughly:
- EPA: 48–100 mg/kg/day
- DHA: 20–32 mg/kg/day (often totaling ~70 mg/kg/day EPA+DHA combined) in osteoarthritis studies.(pubmed.ncbi.nlm.nih.gov pubmed.ncbi.nlm.nih.gov pubmed.ncbi.nlm.nih.gov)
Clinician‑facing guidelines often aim around ~100 mg/kg/day EPA+DHA for joint disease, with a maximum of about 310 mg/kg^0.75 for dogs, but only under veterinary supervision.(caninearthritis.org vetmedbiosci.colostate.edu)
Cats: usually need much lower total amounts based on weight; kidney or heart disease diets may already supply therapeutic levels, so don’t add fish oil without your vet’s approval.(pubmed.ncbi.nlm.nih.gov)
Choosing & Using Omega‑3s
Look for:
- A marine source (fish oil, krill, green‑lipped mussel) rather than flaxseed—dogs and cats convert plant ALA poorly.(caninearthritis.org)
- Clear labeling of EPA and DHA (mg per dose), not just “fish oil.”
- Third‑party testing for purity and oxidation when possible.(vetmedbiosci.colostate.edu)
Safety: Overdosing can cause diarrhea, weight gain, and in theory increased bleeding; most vets reduce or stop fish oil before surgery and monitor pets on anticoagulants.(caninearthritis.org)
Joint Support: Keeping Senior Pets Moving

Joint supplements are among the most common “first purchases” for aging pets—and for good reason.
Key Ingredients
- Glucosamine & Chondroitin: Building blocks of cartilage and joint fluid that may improve comfort and mechanics over time.(toegrips.com cosequin.com)
- MSM (methylsulfonylmethane): Sulfur source that may support cartilage matrix and has mild anti‑inflammatory effects.(toegrips.com)
- Green‑Lipped Mussel (GLM): Provides omega‑3s and glycosaminoglycans; several trials show reduced arthritis pain in dogs.(pubmed.ncbi.nlm.nih.gov petmd.com)
- Hyaluronic Acid (HA): Supports synovial fluid viscosity and joint lubrication.(cosequin.com)
What the Research Says
- A multi‑center randomized, double‑blind trial of 35 dogs with hip/elbow OA found that glucosamine+chondroitin improved pain and weight‑bearing by day 70, similar to carprofen but with slower onset.(pubmed.ncbi.nlm.nih.gov)
- Green‑lipped mussel added to food significantly reduced arthritis scores and joint pain in a 6‑week double‑blind trial in dogs.(pubmed.ncbi.nlm.nih.gov petmd.com)
- Deer velvet and GLM combinations have shown owner‑reported improvements in mobility and vitality in arthritic dogs, though data sets are smaller.(raisingyourpetsnaturally.com toegrips.com)
Typical Use
For a medium dog, many vet‑formulated products start around:
- Glucosamine: ~500–600 mg/day
- Chondroitin: ~300–400 mg/day
- Often with MSM 250–400 mg/day and sometimes HA or GLM, titrated up for larger dogs.(cosequin.com cosequin.com)
Most labels use an initial “loading dose” for 4–6 weeks, then reduce to maintenance if the pet is doing well—though some severely arthritic pets stay on the higher dose long term under veterinary supervision.(toegrips.com)
Don’t Forget the Basics
Supplements work with, not instead of:
- Weight control: Obesity significantly increases OA risk and severity and is now common in middle‑aged and older dogs.(mordorintelligence.com greyB.com)
- Controlled exercise & rehab: Gentle movement, hydrotherapy, and strengthening maintain muscle and joint stability.(greymuzzle.org)
Probiotics: Gut Health for Overall Vitality
The gut microbiome influences digestion, immune function, and arguably even mood and behavior.(vetmedbiosci.colostate.edu pubmed.ncbi.nlm.nih.gov)
Benefits for Senior Pets
- Digestive support: Multiple trials show specific probiotic strains can shorten episodes of acute diarrhea and improve stool quality in dogs.(pubmed.ncbi.nlm.nih.gov pubmed.ncbi.nlm.nih.gov)
- Post‑antibiotic recovery: Probiotics can help stabilize the microbiome and reduce antibiotic‑induced dysbiosis.(pubmed.ncbi.nlm.nih.gov pubmed.ncbi.nlm.nih.gov)
- Immune modulation: Some blends increase fecal IgA and support gut barrier function, which is helpful as immune function ages.(academic.oup.com pubmed.ncbi.nlm.nih.gov)
FortiFlora, for example, uses Enterococcus faecium SF68 at 1×10^8 CFU per gram and is one of the most commonly prescribed veterinary probiotics for diarrhea.(purina.com purina.com.jm)
Dosing
Veterinary sources generally suggest:
- Around 1–10 billion CFU/day total for most dogs, scaled by size and condition.(bestiepaws.com caninebible.com)
Smaller dogs often do well at the lower end (1–3 billion CFU), while large breeds or dogs with chronic GI issues may get more, guided by a vet.(caninebible.com)
Tip: Choose pet‑specific formulas with clearly labeled strains (e.g., Bifidobacterium animalis, Lactobacillus spp., Enterococcus faecium) and guaranteed CFU counts through the expiry date.(vethelpful.com)
Mushroom Blends: Natural Immune and “Anti‑Aging” Allies

Medicinal mushrooms such as turkey tail, reishi, shiitake, lion’s mane, and maitake provide beta‑glucans and other polysaccharides that modulate immune function and oxidative stress.(thebalancedcanine.co.uk pethealthandnutritioncenter.com)
What We Know So Far
- A pilot clinical trial using a turkey tail mushroom polysaccharopeptide (PSP) in dogs with hemangiosarcoma (after splenectomy, no chemo) reported some of the longest median survival times recorded, especially at 100 mg/kg/day, with good tolerance.(hindawi.com dogsnaturallymagazine.com)
- Mushroom beta‑glucans appear to stimulate natural killer cells and other immune functions in animal models and veterinary oncology contexts.(thebalancedcanine.co.uk)
- A 2025 field study commissioned by MycoDog reported that a mushroom‑based supplement led to 81% of senior dogs showing improved or stabilized cognitive scores over 12 weeks, with an average 39% reduction in dysfunction scores; this is encouraging but company‑sponsored.(petfoodindustry.com)
Commercial pet mushroom blends—often combining turkey tail, reishi, shiitake, lion’s mane, etc.—are marketed for immune and brain support, and many document beta‑glucan content.(ferapets.com petshroom.com)
How to Use Them Safely
- Start with manufacturer doses based on weight (often ~25–50 mg/kg of blend, but products vary widely).
- Prioritize organic, tested products with published beta‑glucan percentages.(ferapets.com pethealthandnutritioncenter.com)
- Use extra caution in pets with autoimmune disease or on immunosuppressive drugs—only under veterinary direction.
Cognitive Support: Sharpening the Senior Mind

Cognitive dysfunction syndrome (CDS) in dogs and cats is analogous to human dementia: disorientation, sleep‑wake changes, house soiling, anxiety, and reduced interaction.(todaysveterinarypractice.com theveterinarynurse.com)
Prevalence estimates suggest:
- 28% of dogs aged 11–12 and 68% of dogs 15–16 show signs of CDS.(theveterinarynurse.com)
- Similar age‑linked trends exist in cats.(todaysveterinarypractice.com)
Nutritional Approaches with Evidence
1. Medium‑Chain Triglycerides (MCTs)
Aged brains use glucose less efficiently; MCTs provide an alternative fuel (ketones).(mdpi.com pubmed.ncbi.nlm.nih.gov)
- Several controlled studies in senior dogs show that diets enriched with ~5.5–6.5% MCTs improved performance on learning and memory tasks.(pubmed.ncbi.nlm.nih.gov pubmed.ncbi.nlm.nih.gov)
- A 90‑day clinical study in pet dogs with CDS found that diets with MCTs plus an antioxidant “brain protection blend” improved all six behavior categories vs. control diet.(pubmed.ncbi.nlm.nih.gov)
Commercial diets like Purina Pro Plan NeuroCare use MCTs plus arginine, EPA/DHA, B vitamins, and antioxidants specifically for cognitive and neurologic support.(purina.com purina.com.sg)
2. Antioxidant & “Brain” Blends
Senior dogs on antioxidant‑rich diets (vitamins E and C, fruits/veggies, carnitine, lipoic acid, omega‑3s) show improved learning, memory, and higher brain BDNF levels compared with controls.(mdpi.com pubmed.ncbi.nlm.nih.gov pubmed.ncbi.nlm.nih.gov)
3. Newer Nutraceuticals
Integrative supplements combining antioxidants, Chinese herbs, or NAD+ precursors have shown promising reductions in cognitive scores in small trials, though research is still early and often company‑sponsored.(pubmed.ncbi.nlm.nih.gov nature.com)
Non‑Supplement Essentials
No capsule can replace:
- Daily enrichment (sniff walks, food puzzles, new but gentle experiences).(todaysveterinarypractice.com)
- Routine and predictability to reduce anxiety.
- Good lighting, easy access to beds/litter boxes, and frequent potty breaks.
CBD and Other Emerging Supplements: Proceed with Caution
Cannabidiol (CBD) is widely marketed for senior pets, particularly for pain and anxiety.
- Several small randomized, placebo‑controlled trials report improved pain scores and mobility in dogs with osteoarthritis at doses around 2 mg/kg twice daily, though studies are short and heterogeneous.(frontiersin.org pubmed.ncbi.nlm.nih.gov)
- A recent systematic review concluded CBD is generally safe short‑term and may reduce pain scores, but the certainty of evidence is very low, and liver enzymes can increase.(pubmed.ncbi.nlm.nih.gov pubmed.ncbi.nlm.nih.gov)
Because regulations, product quality, and drug interactions are complex, CBD should only be used under direct veterinary guidance, ideally with products that have third-party testing and clear cannabinoid content.
For many senior pets, you can accomplish a lot with senior pet supplements 2026 like the best supplements for senior dogs and supplements for senior cats—including omega-3 for senior pets, joint support for dogs, probiotics for aging pets, mushroom blends for pets, cognitive support senior dogs, vet-approved pet supplements, and arthritis supplements for pets—along with weight control, pain meds, and rehab before considering CBD.
Real‑World Stories
Case 1:
“Maggie” – Cognitive Improvement with Mushroom + Brain Support
Maggie, a 13‑year‑old mixed‑breed dog, began pacing at night and getting “lost” in corners. Her vet ruled out pain and major disease, then started her on:
- An MCT‑enhanced senior diet with antioxidants, and
- A veterinary mushroom blend containing lion’s mane, reishi, and turkey tail, chosen for documented beta‑glucan content.(mdpi.com ferapets.com)
Over three months, her owner reported better nighttime settling and fewer disorientation episodes, mirroring results from a 12‑week mushroom‑based cognitive study where 81% of dogs improved or stabilized.(petfoodindustry.com)
Case 2:
“Oliver” – Mobility Gains with Omega‑3 + Joint Support
Oliver, a 10‑year‑old spaniel with elbow OA, struggled with stairs. Radiographs confirmed arthritis; his vet prescribed:
- Weight loss plan
- NSAID as needed
- Joint supplement (glucosamine, chondroitin, MSM, GLM)
- Fish oil titrated toward ~70–100 mg/kg EPA+DHA/day.(pubmed.ncbi.nlm.nih.gov caninearthritis.org)
After 2–3 months, his owners noticed easier rising and more willingness to play—consistent with RCTs showing improved weight‑bearing and activity in omega‑3‑supplemented dogs.(pubmed.ncbi.nlm.nih.gov pubmed.ncbi.nlm.nih.gov)
Case 3: “Luna” – Gut Support in a Senior Cat
Luna, a 14‑year‑old cat with early kidney disease, had intermittent soft stools and weight loss. Her vet adjusted her diet, then added:
- A species‑appropriate probiotic containing Enterococcus and Bifidobacterium strains,
- Gradual dose escalation within the 1–3 billion CFU/day range for cats.(caninebible.com purina.com)
Her stools normalized and weight stabilized, illustrating how targeted probiotics can support seniors with concurrent GI and systemic disease.
If anxiety is a concern, explore our detailed 2026 Guide to Dog Separation Anxiety for science-backed strategies.
(These cases are composites based on typical clinical scenarios and published data, not single‑animal trials.)
Building a Safe Supplement Plan for Your Senior Pet

Here’s how to turn all this information into a practical, vet‑approved roadmap.
Step 1:
Start with a Senior Wellness Check
Ask your vet for:
- Full history (mobility, behavior, appetite, elimination, sleep).
- Physical and orthopedic exam.
- Bloodwork, urinalysis ± blood pressure and imaging, based on age and signs.
This determines whether joint pain, kidney disease, endocrine disorders, or other issues should be addressed first—and which supplements are appropriate.(todaysveterinarypractice.com nature.com)
Step 2:
Define 1–2 Primary Goals
Common goals:
- “Improve comfort and mobility.”
- “Support brain aging and night‑time rest.”
- “Stabilize stools and support gut health.”
Clear goals help you and your vet choose fewer, better‑targeted products and measure whether they’re working.
Step 3:
Add Supplements One at a Time
A typical starting stack might be:
- For arthritic but otherwise healthy senior dog:
- Omega‑3 (EPA/DHA)
- Joint supplement
- For disoriented, anxious senior dog (after workup):
- MCT‑enhanced brain diet ± specific cognitive supplement
- Omega‑3s
- For older pet with chronic soft stool:
- Probiotic ± prebiotic fiber
Add one new product every 2–4 weeks so you can link changes (good or bad) to something specific.
Step 4:
Monitor and Re‑Evaluate
Track:
- Energy, mobility, and play.
- Sleep and nighttime restlessness.
- Appetite, stool quality, urinary habits.
Your vet may use validated tools like the Canine Brief Pain Inventory or cognitive rating scales to quantify changes.(pubmed.ncbi.nlm.nih.gov petfoodindustry.com)
Plan to revisit the supplement plan every 6–12 months, or sooner if your pet’s health changes.
Your Next Best Step
Supplements are not magic, but used wisely they’re powerful tools:
- Omega‑3s tame systemic inflammation.
- Joint formulas help protect cartilage and ease stiffness.
- Probiotics support digestion and immunity.
- Mushrooms and antioxidant blends may bolster immune and brain health.
- MCTs and cognitive diets help senior brains stay clearer, longer.
Combine these with thoughtful lifestyle changes and regular veterinary care, and you’re doing a lot to give your older pet more comfortable, joyful years.
Most actionable next step:
Book a senior wellness visit and bring this article (or your notes) to your veterinarian. Ask:
“Given my pet’s age, lab results, and lifestyle, which one or two supplements would you start with, and at what dose?”
From there, you and your vet can build a tailored senior pet supplements 2026 plan—using the best supplements for senior dogs and supplements for senior cats—to fit your pet’s needs, budget, and goal: more good days together.
Conclusion
Vet-approved senior pet supplements 2026 can empower senior dogs and cats to age vibrantly. The best supplements for senior dogs and supplements for senior cats—including omega-3 for senior pets, joint support for dogs, probiotics for aging pets, mushroom blends for pets, cognitive support senior dogs, vet-approved pet supplements, and arthritis supplements for pets—tame inflammation, restore movement, fortify guts, strengthen immunity, and preserve sharpness.
Backed by market trends and surveys showing that pets enhance the coping abilities of many owners, these tools can extend joyful years for your beloved companions. Monitor your pet’s progress, pair senior pet supplements 2026 with regular exercise and vet visits, and embrace a holistic approach to care.
As Dr. Buzby advises, “Supplements bridge gaps, letting seniors live fully.” Your pet deserves this investment—consult with your vet today to create a tailored supplement plan using the best supplements for senior dogs and supplements for senior cats.
Ready to give your senior companion the best years ahead? Explore more science-backed guides on preventive pet wellness, nutrition strategies, managing common age-related challenges like allergies and anxiety, and holistic health tips at PetCastel.
FAQs
Q: How to choose supplements for senior dogs with arthritis?
Look for glucosamine and MSM combinations in arthritis supplements for pets, and consider human-grade options for better quality and noticeable energy gains when selecting senior pet supplements 2026 or the best supplements for senior dogs.
Q: What are the best supplements for senior dogs?
Vets often recommend omega-3 for senior pets to reduce inflammation, joint support for dogs (glucosamine-based), and probiotics for aging pets for digestion as top vet-approved pet supplements in senior pet supplements 2026.
Q: How do joint supplements help older cats?
Glucosamine and chondroitin can reduce stiffness and improve mobility in arthritic senior cats. Brands like GlycoFlex are often recommended by pet owners as effective supplements for senior cats and arthritis supplements for pets.
Q: Are mushroom blends safe for senior pets?
Yes, organic mushroom blends for pets can safely boost immunity and provide cognitive benefits without side effects, making them a good addition to senior pet supplements 2026 for both dogs and cats.
Q: What probiotics work best for aging dogs’ gut health?
Strains like Bifidobacterium in FortiFlora can aid absorption and reduce diarrhea in elderly dogs, standing out as one of the best supplements for senior dogs and top probiotics for aging pets.
Q: Can cognitive support supplements delay senility in cats?
Antioxidants and omega-3 for senior pets can help maintain cognitive function in senior cats, supporting brain health alongside cognitive support senior dogs options adapted for felines in senior pet supplements 2026.
Q: What vitamins should I add to my senior cat’s diet?
Fish oil (rich in omega-3) or vitamin E can support skin health in supplements for senior cats, but it’s best to consult with your vet to avoid over-supplementation when choosing vet-approved pet supplements.
